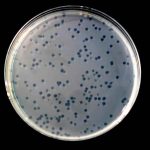

Анализ стихотворения Ф. И. Тютчева «Вечер»
Ф. И. Тютчев «Вечер»
Как тихо
веет над долиной
Далекий колокольный звон,
Как шорох стаи журавлиной,
И в шуме листьев замер он.
Как море вешнее в разливе,
Светлея, не колыхнет день, —
И торопливей, молчаливей
Ложится по долине тень.
1825-1826 г.г.
Анализ стихотворения Ф. И. Тютчева «Вечер»
Стихи Ф. И. Тютчева называют поэзией мысли, философии, любви и даже космического сознания. Ф. М. Достоевский уважал Тютчева, называя первым в России поэтом-философом, которому нет равных, кроме Пушкина. Александр Блок стихотворение Тютчева «Два голоса» считал символом своей жизни, несгибаемой веры.
В поэзии Тютчева перед человеком распахивается Вселенная. Хаос, помещенный в мироздание, смысл человеческой жизни – неподвластная разуму тайна, которую мечтал разгадать поэт. Он понимал мир как первозданную стихию. С этим связано многократное обращение к вечерним сумеркам и «тьме ночной». Время, когда человек находится наедине с вечным миром. И ключ к этому миру, его колыбель – природа.
Федор Иванович – непревзойденный мастер пейзажной лирики. Природа в его стихах одухотворена. Она живет своей особой жизнью. Это драматическая смена состояний. Происходит постоянное движение, динамика, трансформация, взаимодействие природных явлений. В поэзии проходит незримая нить между человеком и природой.
Что значит для человека вечер? Кончается день, его уже не перепишешь заново. Возможно, он был счастливым, полным эмоций, событий. Или наоборот – печальным, совершено много ошибок. Подведены итоги. Завтра будет день новый, который можно прожить совсем иначе. Он как чистый лист. Закат солнца – время спокойствия, гармонии, смирения. В природе происходят неуловимые изменения, которые редко видимы человеческому глазу.
У Ф. И. Тютчева много стихотворений, посвященных вечернему времени. Одно из них с одноименным названием родилось в 1825-1826 г.г. Это был сложный период в жизни поэта. Он только вступил в Государственную коллегию иностранных дел, был командирован в Мюнхен. Надо сказать, что поездка не была рабочей необходимостью.
У юного барина завязался роман с крепостной девушкой Катюшей – наивная, светлая, чистая первая любовь. Отношения молодых людей зашли настолько далеко, что влиятельные родители юноши были вынуждены вмешаться, разорвать союз. Дворяне выхлопотали для сына досрочное окончание университета и заграничную поездку.
Поэт всю молодость проведет заграницей. Катюша Кругликова – единственная любовь лирика, которой не было посвящено стихов. Но грустный след этого чувства читатель может уловить в «Вечере». Автор не использует специальных средств художественной выразительности. В стихотворении нет ни одного эпитета. Оно богато не образами, а звуками. Мельчайшие детали происходящего представлены в аудиальном фоне, что помогает читателю в полной мере представить картину, увиденную рассказчиком.
Где-то слышен колокольный звон. Можно предположить, что это благовест, так как звук одинокий, далекий. Он «веет» над долиной. Приносит покой, становится фоном для картины природы и тяжелых дум автора.
Звуковая доминанта музыкальна, напевна, слышится исключительно вдалеке. До лирического героя долетают только отголоски, своеобразные тени звуков. Вот шорох стаи журавлиной. Его невозможно услышать, но мы знаем, что он есть. Шуршание крыльев улетающих птиц, шелест опадающей листвы говорят читателю о приходе осени.
Второй катрен отличается образностью. Здесь перед нами уже зрительная картина. Появляются яркие метафоры и сравнения. Небо предстает «вешним морем». Оно такое же лазурное, безбрежное, нескончаемое. Создается ощущение бескрайности, безграничности простора. Картина мало похожа на Мюнхен, набережную Изара. Скорее, образ утраченной Родины, Орловской губернии, где вырос поэт.
Автор выбирает самый гармоничный, размеренный стихотворный размер – четырехстопный ямб. Он придает мелодичности лирическому этюду.
Стихотворение оставляет противоречивые эмоции после прочтения. Напевность, размеренность ритма приносят покой. Но есть сомнения, раздумья, ведь рассказчик не знает, что принесет ему утро. Он немного растерян.

А средства выразительности?